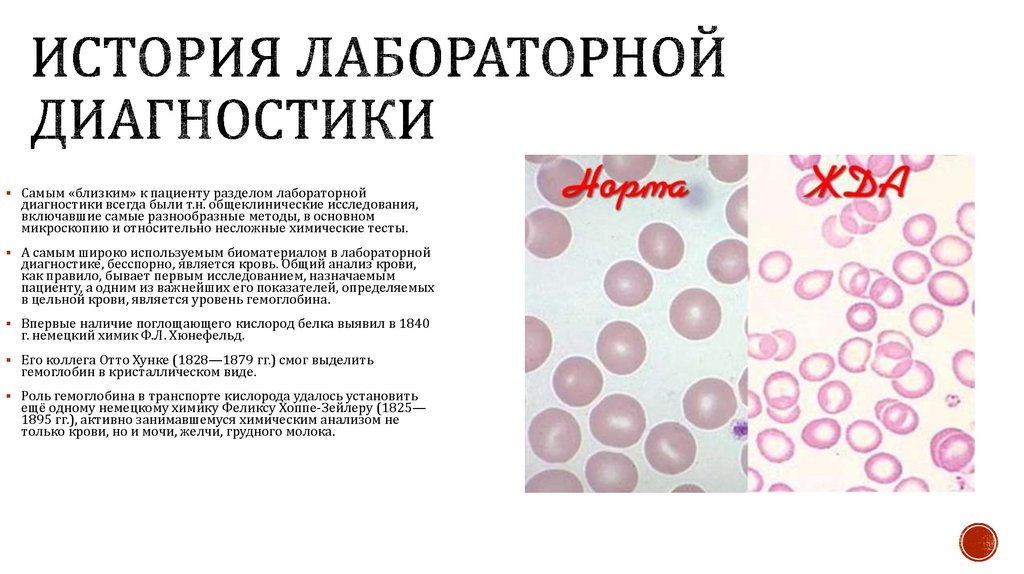
История лабораторной диагностики

Похожие презентации:
Знакомство с лабораторной диагностикой
1. Знакомство с лабораторной диагностикой
2. Общее понятие лабораторной диагностики
Лабораторная диагностика - совокупность физико-химических, биохимических ибиологических методов диагностики, исследующих отклонения в составе и
изменения свойств тканей и биологических жидкостей больного, а также
выявляющих возбудителей болезней. Лабораторные анализы выполняются
практически у всех больных, т.е. значительно чаще, чем другие дополнительные
методы обследования больного (Обследование больного), включая методы
визуализации патологического процесса (Рентгенодиагностика, Ультразвуковая
диагностика, Эндоскопия и др.); среди диагностических исследований в мировой
практике суммарная стоимость лабораторных исследований занимает первое место.
3. Типы основных лабораторных исследований
общеклинические тесты — самые распространенные. К ним относятсяследующие виды анализов: общий анализ крови, общий анализ мочи,
исследование мочи по методу Зимницкого, Нечипоренко, исследование
суточной мочи на сахар, исследование желудочного и дуоденального
содержимого, общий анализ кала, исследование кала на ко- программу, скрытую
кровь, простейшие, яйца гельминтов, изучение состава биологических
жидкостей (экссудата и др.), исследование мокроты и др.;
биохимические — по определению содержания веществ белкового, углеводного,
липидного, пигментного и других обменов веществ в организме человека, а
также остаточного азота и его компонентов, образующихся в процессе
биохимических реакций, активности ферментов в сыворотке, плазме крови и
других биологических жидкостях. Виды анализов: определение общего белка,
белковых фракций, мочевины, креатинина, мочевой кислоты, глюкозы,
трансаминаз (АсТ, АлТ), общего холестерина, билирубина и их фракций,
электролитов мочи и др.;
4. Типы основных лабораторных исследований
иммунологические — определяется степень защиты организма от определенныхзаболеваний, состояние иммунитета (иммунофермен- тативный анализ на ВИЧинфекцию и другие анализы);
серологические — различные способы обследования антиген и антител в крови
пациентов для установления конкретных вирусов и бактерий, вызывающих
инфекционные заболевания. К этому способу относится и определение группы
крови и резус-фактора;
микробиологические — способы выявления возбудителей инфекционно-
воспалительных процессов, определения их чувствительности к лекарственным
препаратам и контроля эффективности лечения (исследование мочи на
микрофлору и чувствительность к антибиотикам и др.);
цитологические — выявление патологических изменений в структуре клеток
организма, диагностика новообразований и другие типы исследований.
5. История лабораторной диагностики
Самым первым учёным,которыйвложил в развитие лабораторной
диагностики, является Луи Пастер.
Пастер сделал ряд выдающихся
открытий. За короткий период с 1857
по 1885 г. он доказал, что брожение
(молочнокислое, спиртовое,
уксуснокислое) не является
химическим процессом, а его вызывают
микроорганизмы; опроверг теорию
самозарождения; открыл явление
анаэробиоза, т.е. возможность жизни
микроорганизмов в отсутствие
кислорода; заложил основы
дезинфекции, асептики и антисептики;
открыл способ предохранения от
инфекционных болезней с помощью
вакцинации.
Луи Пастер, 1822 -1895 гг.
Лактобактерии микроскопия
6. История лабораторной диагностики
Настоящим титаном лабораторной диагностикиможно назвать другого младшего современника
Пастера— немецкого учёного Пауля Эрлиха.
Им были осуществлены фундаментальные
теоретические исследования, приведшие, например,
к формулированию, практически параллельно с
клеточной теорией иммуните-та Мечникова, теории
гуморального иммунитета с основой во
взаимодействии антиген-антитело. Сам термин
«антитело» придуман Эрлихом. Также ему
принадлежитряд научно-практических открытий и
изобретений: пер-вичная дифференцировка
лейкоцитов (лейкоцитарнаяформула),
классификация лейкемий, дуалистическая тео-рия
кроветворения (с разделением красного и серого р о стков), определение роли красного костного мозга,
туч-ных клеток и ретикулоцитов. Создавал и
расширял Эрлихи арсенал практических средств
лабораторной диагности-ки, например, разработал
ряд методов иммуноцитохимии и способов окраски
препаратов биоматериала.
Пауль Эрлих ,1854—1915 гг.
7. История лабораторной диагностики
Очень заметный вклад в расширениевозможностей лабораторной
диагностики внесло появление и
бурное развитие иммунологии.
Возвращаясь к выходцам
Пастеровской лаборатории, нельзя не
вспомнить выдающегося
российского учёного Илью Ильича
Мечникова (1845—1916 гг.),
оставившего глубокий след в
истории ряда медицинских
дисциплин, в том числе
микробиологии, иммунологии,
эмбриологии.
.
Илья Ильич Мечников ,1845-1916 гг.
8. История лабораторной диагностики
Мечников открыл явлениефагоцитоза, создал теорию
воспаления, клеточного
иммунитета и
аутоиммунных реакций. И м
были открыты цитокины,
цитолитические ферменты
и высказано
предположение о наличии
«цитаз» (лизосом).
Фагоцитоз ФЭБ микропрепарат
9. История лабораторной диагностики
Бельгийский микробиолог Жюль Жан-БатистВенсан Борде (1870—1961 гг.) установил, что
в основе иммунных реакций лежат физикохимические процессы. Он открыл механизмы
агглютинации, гемолиза, преципитации,
выяснил роль комплемента, т.о. предложив
серологические исследования и значительно
увеличив их диагностическую ценность.
Также учёный изучал механизмы
анафилаксии, бактериофагии и разработал
одну из первых теорий свёртывания крови. о
наиболее известен Борде благодаря тому, что
совместно с коллегой-соотечественником
Октавом Жангу (1875—1959 гг.) разработал
реакцию связывания комплемента (РСК), в
частности, послужившую основой для метода
диагностики сифилиса.
Жюль Борде, 1870-1961 гг.
Октав Жангу, 1875—1959
10. Реакция агглютинации
(от лат. agglutinatio - склеивание) -склеивание (соединение)
антигеннесущих корпускулярных
частиц молекулами специфических
антител в присутствии
электролитов, которое
заканчивается образованием
видимых невооруженным глазом
хлопьев или осадка (агглютината).
Реакция агглютинации на предметном
стекле в капле сыворотки ориентировочная
Развернутая реакция
агглютинации
11. Направления использования реакции агглютинации
Определение возбудителя, выделенного от больного: используют какагглютинацию на стекле, так и развернутую реакцию.
Определение антител в сыворотке крови больного (развернутая реакция
агглютинации)
Реакция агглютинации для определения групп крови.
12. Реакция связывания комплемента (РСК)
Реакция, основаннаяна взаимодействии
антигена и антитела
с последующей
активацией(связыва
нием) комплемента.
Если комплекс
антиген-антитело не
образуется, то
комплемент остается
свободным.
13. История лабораторной диагностики
Очень серьёзным достижением в областииммунологии и иммунологической диагностики,
послужившим началом для развития подраздела
лабораторных исследований, называемых иногда
«изосерологическими», стало открытие и описание в
1901 г. австрийским иммунологом Карлом
Ландштайнером (1868—1943 гг.) метода выявления
групповых антигенных и серологических отличий у
людей, обладающих разным набором специфических
белков крови (гемолизинов и гемагглютининов).
Смешивая эритроциты одних лиц с нормальными
сыворотками других, ему удалось выявить три
группы крови: А, В и О. Группа АВ была определена в
1907 г. его соотечественником Яном Янски (1873—
1921 гг.).
Карл Ландштейнер, 1868—1943 гг
Ян Янский, 1873—
1921 гг.
14. Реакция непрямой (пассивной) гемагглютинации(РНГА)
склеивание эритроцитовантителами за счет антигенов,
адсорбированных на
поверхности эритроцитов
РНГА ставят в пластиковых
планшетках или в пробирках с
разведениями сыворотки
крови больного, к которым
добавляют антигенный
эритроцитарный диагностикум
– эритроциты с
адсорбированными на них
антигенами
15. Постановка и учет РНГА.
Реакция положительна, еслиобразуется фестончатый
осадок (“кружевной зонтик”).
Реакция отрицательна при
образовании осадка в виде
пуговки.
16. История лабораторной диагностики
Перебрасывая таким образом мостик к историиочередного раздела лабораторной диагностики —
цитологическим исследованиям, можно упомянуть и
известного французского дерматолога Эрнеста Бенье
(1831—1909 гг.). Он первым во Франции создал при
своём дерматологическом отделении гистологическую
(микроскопическую) и бактериологическую
лабораторию, активно пропагандировал метод
биопсии для диагностики и предложил сам термин
«биопсия».
Можно сказать, что основы цитологической
диагностики были заложены ещё в 1860-е годы.
Немецкий анатом Генрих Вильгельм Готфрид фон
Вальдейер-Гарц (1836—1921 гг.), занимавшийся
классификацией различных клеток человеческого
организма, высказал предположение, что
новообразования могут развиваться из одной клетки и
распространяться с током крови или лимфы. Он
разработал гистологический метод и первые
цитологические критерии диагностики
онкологических заболеваний.
*Биопсия — диагностическая процедура, которую проводят с целью получения
образца ткани (биоптата) из «подозрительного» места, например, опухоли или
полипа.
- Биопсия необходима для подтверждения диагноза при онкологических
заболеваниях.
Эрнест Бенье, 1831—1909 гг
Генрих Вильгельм Готфрид фон
Вальдейер-Гарц, 1836—1921 гг.,
17. История лабораторной диагностики
Активно и повсеместно цитологическиеисследования стали внедряться в
практику с 1920-х годов. В 1927 г.
советский гематолог Михаил
Иннокентьевич Аринкин предложил
методику стернальной пункции с
последующим микроскопическим
изучением состояния красного
костного мозга.
Большой вклад в продвижение
цитологического метода в СССР,
особенно для диагностики поражений
костного мозга, лимфоузлов и
селезёнки внёс Иосиф Абрамович
Кассирский (1898—1971 гг.), известный
также своими достижениями в
изучении морфологии и цитохимии
клеток крови.
Михаил Иннокентьевич Аринкин,
1876- 1948 гг.
Иосиф Абрамович Кассирский,
1898—1971 гг.
18.
19. История лабораторной диагностики
Самым «близким» к пациенту разделом лабораторнойдиагностики всегда были т.н. общеклинические исследования,
включавшие самые разнообразные методы, в основном
микроскопию и относительно несложные химические тесты.
А самым широко используемым биоматериалом в лабораторной
диагностике, бесспорно, является кровь. Общий анализ крови,
как правило, бывает первым исследованием, назначаемым
пациенту, а одним из важнейших его показателей, определяемых
в цельной крови, является уровень гемоглобина.
Впервые наличие поглощающего кислород белка выявил в 1840
г. немецкий химик Ф.Л. Хюнефельд.
Его коллега Отто Хунке (1828—1879 гг.) смог выделить
гемоглобин в кристаллическом виде.
Роль гемоглобина в транспорте кислорода удалось установить
ещё одному немецкому химику Феликсу Хоппе-Зейлеру (1825—
1895 гг.), активно занимавшемуся химическим анализом не
только крови, но и мочи, желчи, грудного молока.
20. История лабораторной диагностики
в 1959 г., т.е. позже, чем кажущаясякуда более сложной «расшифровка»
ДНК, структура гемоглобина была
определена британскими
биохимиками — нобелевскими
лауреатами: Джоном Коуэри
Кендрю (1917—1997 гг.) и Максом
Фердинандом Перуцем.
Джон Коуэри Кендрю, 1917—1997 гг.
Макс Фердинанд Перуцем, 1914 2002 гг.
21. История лабораторной диагностики
Какое значение такому биоматериалу, как моча,придавалось всредневековой медицине, сказано выше довклинические исследования
стали проводиться только в XIX в. Одним ольно много, н о настоящие
научно подкреплённые из первых в этой области являлся английский
врач Ричард Брайт (1789—1858 гг.), носяший гордое имя Отца
нефрологии. Брайт организовал маленькую пригоспитальную
лабораторию, где с помощью химика Джона Бостока (1773—1846 гг.)
осуществлял макроскопический, физический и химический анализ
мочи. Применялась п аровая баня для подогрева остывшей мочи.
Изучая гломерулонефриты, Брайт часто определял в моче альбумин
при помощи ложки, в которой нагревал мочу над свечой. Если в моче
был альбумин, то он оседал при нагревании чуть нижее точки кипения
в виде творожистого осадка. Правда, при столь серьёзном отношении к
лабораторным методам в целом, Брайт мог претендовать и на
сомнительную славу последнего известного клинициста, с успехом
обходившегося «традиционной» уроскопией и не пользовавшегося
микроскопом.
В 1850—1860 гг. комплексные исследования мочи, включавшие как
микроскопию, так и химико-физический анализ с определением:
хлоридов, сульфатов, фосфатов, мочевины и глюкозы, проводил другой
английский врач Артур Хилл Хоссэл (1817—1994 гг.), известный своими
гистологическими исследованиями тимуса. Учёным были отмечены
значительные различия состава мочи в зависимости от пола, возраста и
влияния разных патологических состояний.
Ричард Брайт, 1789—1858 гг.
Джон Босток ,1773—1846 гг
22.
23. История лабораторной диагностики
Планомерное микроскопическое изучение кала началось лишь в XIX в. В1836 г. во Франции были опубликованы первые микроскопические
наблюдения над испражнениями тифозных больных. В 1842 г. впервые
появились описания обнаруженных в кале различных растительных клеток
и их конгломератов, а также капелек жира, кристалликов, клеток эпителия
кишечных желез, кровяных и гнойных клеток. Санитарный врач и хирург,
один из основоположников общественной гигиены в Англии Джон Саймон
(1816—1904 гг.) в своем «Руководстве по медицинской химии» 1842 г.
приводит описание имеющихся в кале пищевых остатков: мышечных
волокон, связок, жира, а также элементов, выделяемых кишечной стенкой
или образующихся в самом кишечном содержимом: капель холестерина,
кристаллов трипельфосфатов и т.п. Он также обратил внимание на
различный состав кала новорожденного, грудного ребёнка и взрослого. Там
же можно найти описание многих кишечных заболеваний, при которых
наблюдаются химические и микроскопические изменения кала. Саймон
также упоминает об изменении цвета кала при кишечных кровотечениях —
меле- не, и при желтухе — acholia, в кале желтушных больных он также
отмечал кристаллы «маргарина», видимо, туго- плавких жирных кислот.
Англии Джон Саймон,1816—1904 гг.
24.
25. Инструменты и приборы для лабораторных исследований
26.
27. Профессия Лабораторной диагностикой
Лаборант или лабораторный техник – научнотехнический сотрудник лаборатории медицинского,учебного или научного учреждения. Он выполняет
практическую работу в области научных исследований,
разработок и анализа. Достаточно часто лаборанты
работают в тесном сотрудничестве с ученымиестествоиспытателями и инженерами в
исследовательских, опытно-конструкторских и
производственных лабораториях.
28. Историческая справка
Историки подтверждают, что впервые лаборантыпоявились еще в средние века. В то время особенным
авторитетом пользовались университеты Италии и
Австрии, где ежедневно приходилось готовить аудитории
к приему студентов медицинских факультетов.
Эта тяжелая работа сбрасывалась на плечи лаборантов. Им
приходилось не просто расставлять пробирки и
инструменты для препарирования лягушек, а еще и искать
материал для исследования, либо покупать его у местных
жителей. Считается, что большинство античных
мыслителей и прародителей различных биологических,
геологических и химических теорий до ХІІ предпочитали
свои опыты ставить самостоятельно. При этом далеко не
все историки согласны с таким стереотипом, так как во
многих экспериментах, описывающихся в старых
постулатах, участвовать одному для достижения нужного
итога было попросту невозможно. Отсюда рождается
теория, что уже тогда младшие сотрудники помогали
великим творить знаменательные открытия, оставаясь в
тени.
29. Вывод
История лабораторной диагностики продолжаетсоздаваться и методы лабораторной диагностики
приобретают все большее значение как для
практической так и для теоретической медицины.